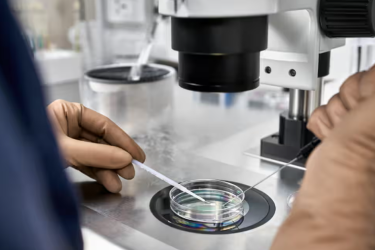

Thanh niên ở Hà Lan được đề nghị xét nghiệm ADN trước khi hẹn hò vì có thể yêu nhầm người có quan hệ huyết thống.
CÔNG TY CỔ PHẦN ĐẠI SÀN

Giấp phép đăng ký kinh doanh số 0103884103 do Sở Kế Hoạch & Đầu Tư Hà Nội cấp lần đầu ngày 29/06/2009.
Trụ sở chính: Gian số L4-07 tầng 4, nơ-2 - Gold Season, 47 Nguyễn Tuân, Thanh Xuân, Hà Nội
Email: info@daisan.vn
TRỤ SỞ HÀ NỘI
Gian số L4-07 tầng 4, nơ-2 - Gold Season, 47 Nguyễn Tuân, Thanh Xuân, Hà Nội
![]() Điện thoại: 1900 98 98 36
Điện thoại: 1900 98 98 36
![]() Fax: 045625169
Fax: 045625169
CHI NHÁNH HỒ CHÍ MINH
57/1c, Khu phố 1, Phường An Phú Đông, Quận 12, Thành phố Hồ Chí Minh
![]() Email: info@daisan.vn
Email: info@daisan.vn